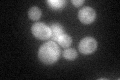
YHR201C
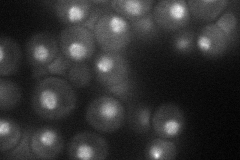
YHR201C
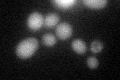
YHR201C

View description
Exopolyphosphatase, hydrolyzes inorganic polyphosphate (poly P) into Pi residues; located in the cytosol, plasma membrane, and mitochondrial matrix
Localization:
Intensity:
Fold change:
Significance:
-
C’ GFP library in SD
cytosol45.16 -
N' NOP1pr-GFP in SD
punctate,nucleus35.7493 -
N' TEF2pr-mCherry in SD

punctate,nucleus30.6329 -
N' NATIVEpr-GFP in SD

ambiguous,ER22.8345 -
N' TEF2pr-VC and Cyto-VN in SD

#N/A0 -
C’ GFP library in SD+DTT

cytosol46.881.03No -
C’ GFP library in SD+H2O2

cytosol43.170.95No -
C’ GFP library in Starvation Media
cytosol64.081.41Yes -
C’ GFP library on the background of Pup2-DaMP

cytosol -
C’ GFP library on the background of CCT mutant

cytosol44.75750.990811No
